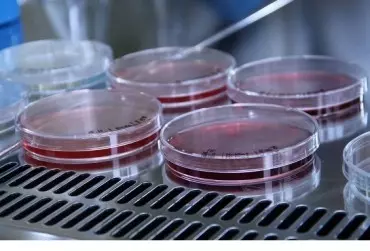

Daj się ponieść kulinarnemu szaleństwu i wzbogacić spotkanie w gronie najbliższych kolorowymi, chrupkimi przekąskami OLE!. Party Mix to połączenie różnych marynowanych warzyw, dzięki czemu każdy znajdzie wśród nich coś dla siebie.
Kategoria: Artykuł
Nowa generacja innowacyjnych produktów bazujących na drożdżach Yarrowia lipolytica – polski novel food, pojawi się na rynku już w IV kwartale 2020 roku.
Skotan S.A. podpisał umowę ze spółką Life Beauty Pharma na komercjalizację polskiego superfood - Yarrowia lipolytica Novel Food wpisanego do unijnego wykazu nowej żywności zgodnego z Rozporządzeniem Parlamentu Europejskiego i Rady (UE) 2015/2283 [...]. Owocem tej współpracy będzie wprowadzenie do sprzedaży br. nowych produktów w kategorii tzw. meal replacement. Life Beauty Pharma zapowiada rozpoczęcie ich sprzedaży jeszcze w 2020 r.
Od 6 miesięcy wszyscy żyjemy w nowej rzeczywistości społecznej. Na nowo definiujemy „starą” higienę, przypominamy sobie dawno zapomniane zasady bezpieczeństwa w miejscach publicznych. Dezynfekujemy otoczenie w wymiarze nie do pomyślenia jeszcze rok temu. Biomy się korzystać z pomocy lekarzy w przychodniach. Nikt z nas nie wie, jak długo przyjdzie nam żyć w aktywnej obecności koronowirusa. Wiemy natomiast, że potrzebujemy świadomej i skutecznej troski o siebie nawzajem.
Dieta matki karmiącej to temat, wokół którego narosło bardzo dużo mitów. Szczególnie popularny jest pogląd, że kobieta w okresie laktacji powinna zapomnieć o swoich ulubionych potrawach, kawie czy mleku i ograniczyć się niemal wyłącznie do gotowanego kurczaka, ryżu i marchewki. Ile prawdy jest w tym poglądzie? Karolina Pityńska-Maga, położna i ekspert marki Mama i ja, wody źródlanej dedykowanej dzieciom i kobietom w ciąży, zdradza, jak powinno wyglądać menu młodej mamy i jaki wpływ na dziecko mają spożywane przez nią pokarmy.
Nestlé intensyfikuje działania, dzięki którym do 2025 roku 100% opakowań firmy będzie nadawać się do recyklingu bądź ponownego wykorzystania, i które pozwolą zmniejszyć zużycie pierwotnych tworzyw sztucznych o jedną trzecią.
Sieć handlowa Netto obchodzi jubileusz 25-lecia obecności na polskim rynku. Z tej okazji, w poniedziałek, 7 września, rusza Wielka Urodzinowa Loteria. Na klientów czekają bardzo atrakcyjne nagrody, a ich łączna pula wynosi aż 175 tysięcy!
Ser halloumi to rarytas pochodzący prosto z Cypru, gdzie jest produkowany i traktowany niemalże jako prawdziwe dobro narodowe. Nic dziwnego - to wyjątkowo smaczny produkt, który wytwarzany jest z mleka owczego, często z dodatkiem mleka koziego i krowiego oraz mięty. Ser halloumi można spożywać solo lub jako dodatek do wielu dań - na surowo, w wersji smażonej lub grillowanej. Wykorzystanie sera halloumi jako dodatku do pełnej warzyw bagietki z sosem do Frytek Curry od Roleski to sposób na przeniesienie się wprost do cypryjskich tawern.
Bez względu na wiek każdy uwielbia jeść. Chociaż wiele osób może lubić te same potrawy i restauracje, mogą mieć zupełnie inne nawyki żywieniowe. Sprawdźcie, jak różne są preferencje trzech popularnych grup: Baby Boomers, Millenialsów oraz pokolenia Z.
Koniec z nieprawdziwymi informacjami i powielanymi stereotypami – właśnie taki jest cel najnowszej kampanii edukacyjno-informacyjnej Krajowej Rady Drobiarstwa – Izby Gospodarczej. Ma ona obalić mity, które narosły wokół sektora drobiarskiego. Głównym przekazem kampanii jest hasło „FAŁSZ W…KURZA”, nawiązujące bezpośrednio do rozpowszechnianych przez niektóre organizacje w przestrzeni publicznej mitów dotyczących mięsa drobiowego.
W poniedziałek, 7 września, w sklepach dyskontu rusza kolejna akcja lojalnościowa, zatytułowana „Mistrzowska akcja w Netto”. Nowa odsłona programu skierowana jest do klientów poszukujących kulinarnych inspiracji. W zamian za zakupy, otrzymają oni rabat na wysokiej jakości garnki i patelnie marki MasterChef.
Legendarna marka wody mineralnej wprowadza nowe warianty smakowe, uruchamia profil na Instagramie i nawiązuje współpracę z polskimi influencerami.
Wylecz nadciśnienie i zadbaj o piękną sylwetkę.